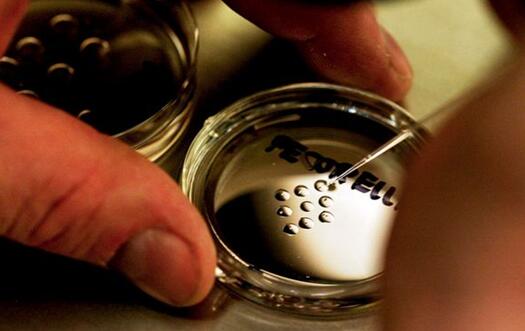
培養(yǎng)皿上的人類胚胎

科學(xué)家利用最前沿的微型器官,打造“人體芯片”進(jìn)行新藥測(cè)試
據(jù)報(bào)道,英國和美國的研究團(tuán)隊(duì)發(fā)明出7種微型人體器官,并將它們整合在一起,創(chuàng)建出世界上第一款“人體芯片”。這款微型人體再造器官芯片,使用了真正的人類器官組織來模擬人體實(shí)際的生理機(jī)能。
現(xiàn)代科學(xué)可以改變制藥公司開發(fā)新藥的模式,并且有可能終結(jié)動(dòng)物實(shí)驗(yàn)。

麻省理工學(xué)院研制出的擁有7種“器官”的人體芯片
據(jù)報(bào)道,英國和美國的研究團(tuán)隊(duì)發(fā)明出7種微型人體器官,并將它們整合在一起,創(chuàng)建出世界上第一款“人體芯片”。
在馬薩諸塞州波士頓舉行的2016年全球器官芯片會(huì)議上,位于牛津郡CN Bio Innovations公司的科學(xué)家們首次將這款造價(jià)2600萬美元的“人體芯片”公之于眾。
這款微型人體再造器官芯片,使用了真正的人類器官組織來模擬人體實(shí)際的生理機(jī)能。
這種類似“機(jī)械戰(zhàn)警”的半人半機(jī)械設(shè)計(jì),確實(shí)能幫助科學(xué)家探索更安全、更有效的藥物。

器官芯片可以變革藥物測(cè)試
終結(jié)動(dòng)物實(shí)驗(yàn)
這款新奇的半有機(jī)迷你芯片的基本功能是測(cè)試新型藥物。
事實(shí)上,它看起來像一個(gè)大型電路板。不同于使用銅線電路進(jìn)行電力輸送,這款芯片的內(nèi)部使用狹窄的通道來轉(zhuǎn)運(yùn)血液模仿液。
我們不該對(duì)這款芯片的人體相似度的缺乏抓住不放,而反對(duì)這類小型器件的應(yīng)用,因?yàn)檫@將有可能改變制藥公司的新藥開發(fā)和對(duì)現(xiàn)有藥物的測(cè)試方法。
想象一下,制藥公司不再觀察新藥對(duì)實(shí)驗(yàn)室小白鼠所產(chǎn)生的藥物反應(yīng),而能夠利用實(shí)驗(yàn)室中精確再創(chuàng)造的人體器官來測(cè)試新型藥物。
英國CN Bio公司的首席執(zhí)行官Emma Sceats博士在波士頓舉行的會(huì)議上指出:“制藥公司并不喜歡動(dòng)物實(shí)驗(yàn)。”
事實(shí)上,由于受動(dòng)物實(shí)驗(yàn)的局限,制藥公司已經(jīng)開始使用單獨(dú)的器官芯片和其它人體細(xì)胞技術(shù)來測(cè)試新藥的藥效。

制藥公司認(rèn)為人造器官將終結(jié)動(dòng)物實(shí)驗(yàn)
人體芯片項(xiàng)目的靈感來自Barry Pallotta博士,他是美國國防高級(jí)研究計(jì)劃局(美國國防部的一個(gè)部門)的項(xiàng)目經(jīng)理。
Pallotta在2015年提出想要找到能改善新藥和疫苗開發(fā)的新方法。他解釋說到:“我知道現(xiàn)在的新藥和疫苗開發(fā)方法并不完善,因此我想要做出自己的努力?!?/span>
他提出的設(shè)想是制作一個(gè)分析盒,里面的人體細(xì)胞可以對(duì)候選疫苗或藥物做出與真實(shí)人體完全相同的給藥反應(yīng)。
美國國防高級(jí)研究計(jì)劃局最終資助了幾個(gè)芯片項(xiàng)目。本文中的人體芯片項(xiàng)目基于麻省理工學(xué)院的Linda Griffith教授首創(chuàng)的技術(shù),是Griffith教授的研究團(tuán)隊(duì)與CN Bio Innovations通力合作的研究成果。
“人體芯片”——在實(shí)驗(yàn)室中再造人體器官
內(nèi)嵌在微流控“人體芯片”器件的通道和微泵擁有真實(shí)、具有正常功能的器官組織。
這些組織可以通過干細(xì)胞或外科手術(shù)期間收集的人體組織來培養(yǎng)獲得。
這些“器官”放置在三維支架之上進(jìn)行培養(yǎng),方便組織生長(zhǎng)獲得自然結(jié)構(gòu)。
Sceats博士指出:“細(xì)胞不喜歡培養(yǎng)皿中的生長(zhǎng)環(huán)境,相比硬的塑料,它們更青睞于生長(zhǎng)在被其它細(xì)胞包圍的環(huán)境之中”。
在人體內(nèi)部,氧氣和食物通過血液循壞提供給器官。再造人體器官則通過通道連接,將富含氧氣、營(yíng)養(yǎng)豐富的液體泵送到器官的各個(gè)部位。
培養(yǎng)皿上的人類胚胎
維持所有的器官存活是一個(gè)巨大的挑戰(zhàn)?!爱?dāng)我們做藥物測(cè)試時(shí),必須保持所有器官至少存活3周以上?!?Sceats博士表示。
最終形式
人體芯片的最終形式將擁有10種器官——肝、腸、心、腎、腦、肺、生殖系統(tǒng)、免疫系統(tǒng)、血管系統(tǒng)和皮膚。
研究員們將能夠監(jiān)控藥物對(duì)實(shí)驗(yàn)臺(tái)上“人體”的藥物反應(yīng),并最終勘察出藥物對(duì)不同器官或整個(gè)系統(tǒng)總體而言是有毒還是有效。
CN Bio公司的專長(zhǎng)是制作微流控肝芯片,現(xiàn)有技術(shù)對(duì)肝病的治療采取的是肝移植的療法,Sceats博士希望借此技術(shù)改善肝病的治療。
她希望通過這項(xiàng)技術(shù)進(jìn)行治療方法測(cè)試,病人只需要一種藥物或某種干細(xì)胞治療方法,最終可使器官自身獲得原位修復(fù)。

CN Bio公司的肝芯片
她也設(shè)想過使人體芯片成為非常強(qiáng)大的測(cè)試工具,但是存在潛在風(fēng)險(xiǎn)的基因療法需要使用“分子剪刀”來改變病人原有的基因組。
這些基因療法將有可能幫助醫(yī)生治療遺傳性基因疾病。
談到上述治療可能會(huì)對(duì)病人造成的風(fēng)險(xiǎn),Sceats博士說到:“我們必須對(duì)此萬分謹(jǐn)慎,確保最終結(jié)果的正確性,器官芯片將是基因療法最理想的測(cè)試工具?!?/span>
來源:麥姆斯資訊
標(biāo)簽:   人體芯片 器官芯片 微流控
